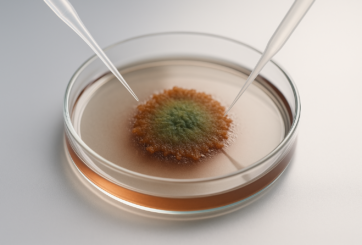
AI Generated Image

Die Abwehr von Krankheitserregern ist ein Kraftakt für den Körper, der mit hoher Präzision und Geschwindigkeit erfolgen muss. Ein Forschungsteam am CeMM und der MedUni Wien hat unter der Leitung von Christoph Bock und Matthias Farlik untersucht, wie Immunzellen diese Aufgabe meistern. Ihre in Cell Systems veröffentlichte Studie (DOI: 10.1016/j.cels.2025.101346) liefert eine Analyse der molekularen Prozesse in den „Fresszellen“ (Makrophagen) unseres Immunsystems, während sie verschiedene Krankheitserreger bekämpfen. Die Forscher entwickelten dafür eine neue Methode, um mit Hilfe der CRISPR-Genschere und…

Künstliche Proteine gezielt mit einzigartigen Eigenschaften herstellen – das ist möglich mithilfe einer neuartigen Methode, die ein Forschungsteam unter Leitung von Prof. Dr. Dominik Niopek am Institut für Pharmazie und Molekulare Biotechnologie (IPMB) der Universität Heidelberg entwickelt hat. Im Zentrum steht dabei ein neues KI-Modell. Damit lässt sich vorhersagen, wie zwei Proteine aus Einzelteilen – den Untereinheiten – auf molekularer Ebene zusammengefügt werden müssen, um ein funktionales und regulierbares neues Protein zu erzeugen. Dieses als ProDomino bezeichnete Open-Source-Werkzeug eröffnet vielfältige…

HU-Forschende entwickeln lichtbetriebenen Nano-Motor und erzeugen damit ringförmige Moleküle, die wie Glieder einer Kette ineinander verschlungen sind ++ Bitte beachten Sie die Sperrfrist: 31. Juli 2025, 20 Uhr MESZ (14 Uhr EST) ++ Fäden und Seile eignen sich hervorragend zum Flechten, Knoten und Weben. In der Chemie dagegen ist eine derartige Verarbeitung von Molekülsträngen eine fast unlösbare Herausforderung. Denn Moleküle sind nicht nur winzig klein, sie sind ständig in Bewegung und lassen sich daher nicht ohne weiteres anfassen, halten oder…

Freilebende Fischgruppen erkennen Gefahren schneller und reagieren treffsicherer, je größer sie sind Wenn ein Raubvogel angreift, zählt für Fische jede Sekunde: abtauchen oder bleiben? Eine falsche Entscheidung kann tödlich enden – entweder, weil sie zu spät kommt oder weil eine Bedrohung fälschlich als harmloses Geräusch gewertet wird. Eine Studie von Forschenden des Exzellenzclusters „Science of Intelligence“ (SCIoI) sowie der Humboldt-Universität zu Berlin (HU) und des Leibniz-Instituts für Gewässerökologie und Binnenfischerei (IGB) zeigt nun, dass größere Fischschwärme solche Entscheidungen nicht nur…

Forschende der Universität Basel haben ein natürliches Enzym so verändert, dass es eine höchst anspruchsvolle chemische Reaktion katalysiert. Komplexe Moleküle für Arzneistoffe und Feinchemikalien könnten dadurch umweltfreundlicher und effizienter hergestellt werden. Katalysatoren gehören zu den wichtigsten Werkzeugen auf dem Weg zu einer nachhaltigeren grünen Chemie. Sie beschleunigen chemische Reaktionen, machen sie effizienter und besser steuerbar. Dadurch können bei der Herstellung von verschiedensten Produkten Energie, Abfall und Kosten eingespart werden. Die Suche nach neuen Katalysatoren beschäftigt die Chemie durchgehend seit dem…

Forschende der RWTH untersuchen epigenetische Schalter im Gehirn am Mausmodell – Ergebnisse in Nature Communications veröffentlicht Wenn wichtige molekulare Schalter der Genregulation im Gehirn fehlen oder nicht mehr funktionieren, kann das gravierende Folgen für die Entwicklung eines Menschen haben – mit möglichen Folgen wie Schizophrenie, Autismus und Epilepsie. Forschende der RWTH haben nun im Mausmodell untersucht, welche Rolle das Enzym DNMT1 dabei spielt. Die Ergebnisse wurden in der renommierten Fachzeitschrift Nature Communications veröffentlicht. Ein Team um Professorin Geraldine Zimmer-Bensch fand…
Forschende der Universität Bern haben in Zusammenarbeit mit Forschenden aus Australien und Neuseeland einen bedeutenden Prozess im Labor nachgebaut, der es Organismen ermöglicht, Energie direkt aus der Luft zu gewinnen. Damit bestätigen sie, dass gewisse Organismen wie Bakterien tatsächlich nur von Luft leben können, ohne auf Sonnenlicht oder andere Energiequellen angewiesen zu sein. Die Erkenntnisse zeigen neue Möglichkeiten zur nachhaltigen Energiegewinnung auf. Wasserstoff kommt in unserer Atmosphäre nur als Spurengas vor, in einer Konzentration von 0.00005%. Die Konzentration bleibt dabei…

2003 konnte das menschliche Genom im Human Genome Project (HGP) erstmals zu mehr als 90 Prozent abgebildet werden. Das 1000 Genome Project (2007-2015), bei dem die Daten von über 2.500 Menschen zusammengetragen wurden, bot dann erste Einblicke in die Vielfalt des menschlichen Genoms. Jetzt wurden die Proben durch eine internationale Forschungsgruppe unter Zusammenarbeit mit Prof. Dr. Tobias Marschall, Genominformatiker an der Heinrich-Heine-Universität Düsseldorf (HHU), erneut analysiert. Die daraus resultierenden Ergebnisse werden nun in zwei Veröffentlichungen in der Fachzeitschrift Nature vorgestellt….

In lebenden Zellen sind Moleküle ständig in Bewegung – sie wandern durch die Zelle, interagieren und gehen Bindungen ein. Ein internationaler Wettbewerb, die 2. AnDi Challenge, hat nun einen systematischen Vergleich von Methoden zur Bewegungsanalyse von Einzelmolekülen geliefert, der sowohl die aktuellen Stärken als auch die dringenden Herausforderungen in diesem sich rasch entwickelnden Bereich aufzeigt. In der komplexen Welt der lebenden Zellen können die Bewegungen von Molekülen entscheidende Hinweise darauf geben, wie Zellen funktionieren, kommunizieren und manchmal auch versagen. Doch…

Eine neue Studie zeigt, dass das weit verbreitete Blutprotein Albumin normalerweise harmlose Pilzstämme von Candida albicans in gefährliche Krankheitserreger verwandeln kannUnter Leitung des Leibniz-HKI in Jena haben Forschende einen neuen Weg entdeckt, wie die Hefe Candida albicans menschliches Gewebe schädigen kann. Im Fachjournal „Nature Communications“ beschreiben sie einen alternativen Infektionsweg, an dem das menschliche Serumprotein Albumin beteiligt ist. Dieser Mechanismus war bisher nicht beschrieben und könnte erklären, warum bestimmte klinische Isolate von Candida albicans in Laborversuchen harmlos erscheinen, bei Patient*innen…

Chemie-Forschungsteam der Universität Jena beeinflusst Spin eines Moleküls erstmals direkt durch ein elektrisches Feld Vor einigen Jahren entwickelten Chemiker der Friedrich-Schiller-Universität Jena ein Molekül, das als potenzielles Qubit – also als Recheneinheit in einem Quantencomputer – funktionieren kann. Mithilfe dieses Kupferkomplexes haben sie nun gemeinsam mit Kolleginnen und Kollegen der Universität Florenz die Möglichkeiten für zukünftige Entwicklungen in der Quantentechnologie enorm vergrößert. Denn erstmals gelang es ihnen, den Spin Zustand eines Moleküls direkt mit elektrischen Feldern zu steuern, indem man…

Eine einzigartige evolutionäre Lösung für den Fortbestand männlicher Tiere haben Vögel in Form einer wirkungsvollen Mikro-RNA ausgebildet. Dieses winzige Gen sorgt dafür, dass männliche Embryonen trotz eines genetischen Ungleichgewichts zwischen den Geschlechtern überleben können, indem es die Aktivität von Geschlechtschromosomen ausbalanciert. Das hat ein internationales Forschungsteam unter Leitung von Biologen der Universität Heidelberg und der University of Edinburgh (Schottland) herausgefunden. Dieser Mechanismus war bislang nicht bekannt und unterscheidet sich deutlich von dem System, das Säugetiere im Laufe der Evolution für…

Anfang Juli hat die Deutsche Forschungsgemeinschaft (DFG) verkündet, eine neue Forschungsgruppe an der TU Dortmund einzurichten. Prof. Andreas Steffen von der Fakultät für Chemie und Chemische Biologie ist Sprecher des Verbunds mit dem Namen „STIL-COCOs“, an dem sechs weitere Einrichtungen beteiligt sind. Gemeinsam werden die Partner smarte Leuchtmaterialien für photonische Technologien entwickeln. Die DFG fördert das Projekt für zunächst vier Jahre mit rund 3,7 Millionen Euro. Photonische Technologien sind aus unserem Alltag nicht mehr wegzudenken: Sie stecken in OLED-Displays, Lasersystemen…

Wie viel Mikroplastik steckt in Fisch und Meeresfrüchten, die auf unseren Tellern landen? Die Angaben schwanken stark. Das liegt auch daran, dass der Lebensmittelüberwachung standardisierte Analyseverfahren fehlen, um die winzigen Kunststoffpartikel in Fischereierzeugnissen quantitativ nachzuweisen. Dadurch lassen sich die Ergebnisse unterschiedlicher Studien nur schwer bewerten und oft ist unklar, wie zuverlässig vorliegende Daten sind. Wissenschaftlerinnen und Wissenschaftler des Max Rubner-Instituts haben Methoden aus der Umweltanalytik weiterentwickelt, um sie für die Untersuchung von Mikroplastik in Fisch und Meeresfrüchten nutzbar zu machen….

Neue Forschungsergebnisse aus einer Zusammenarbeit zwischen den Laboren von Stefan Mundlos (Max-Planck-Institut für Molekulare Genetik, Berlin), Dario G. Lupiáñez (Centro Andaluz de Biología del Desarrollo, Sevilla, Spanien/Max Delbrück Center, Berlin) und Francisca M. Real (Centro Andaluz de Biología del Desarrollo/MPI für Molekulare Genetik) zeigen, wie genetische Programme in der Evolution des Säugetierflugs wiederverwendet werden. Der Wunsch zu fliegen hat die Menschheit immer begleitet. In der Evolution wurde die Fähigkeit zu fliegen nur dreimal, und das voneinander unabhängig, entwickelt: In den…

Hochauflösende Kryo-Elektronenmikroskopie macht es möglich, komplexe enzymatische Prozesse detailliert zu untersuchen. Einem Forschungsteam der Universität Potsdam und der Humboldt-Universität zu Berlin ist es mit dieser Methode gelungen, den Enzymkomplex CODH/ACS genau zu charakterisieren. Sie haben dabei herausgefunden, dass sich der Komplex im Verlauf chemischer Reaktionen bewegt und so die Reaktionsfolge bestimmt. Ihre Ergebnisse sind nun im Journal „Nature Catalysis“ erschienen. Bevor in der Erdgeschichte die Photosynthese einsetzte und sich Sauerstoff in der Atmosphäre anreicherte, lebten hier im Wesentlichen anaerobe Mikroorganismen,…